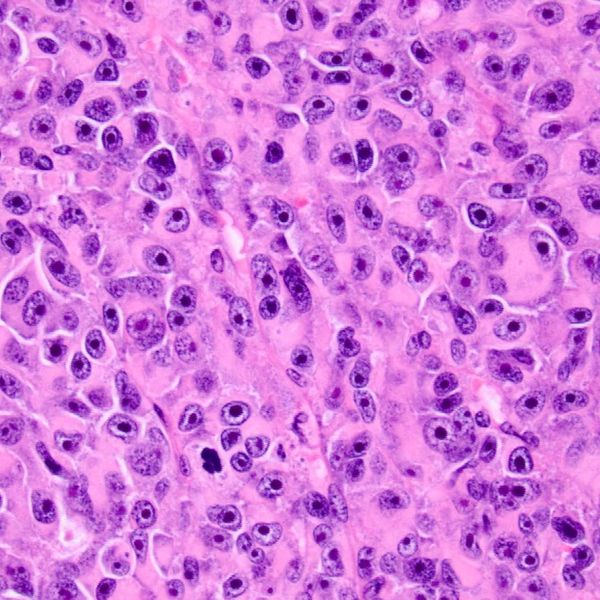

Melanoma is a type of cancer that develops in the cells that produce melanin — the pigment that gives skin its color. Your eyes also have melanin producing cells and can develop melanoma. Eye melanoma is also called ocular melanoma. Most ocular melanomas form in the part of the eye you can't see when looking into a mirror. This makes ocular melanoma difficult to detect. In addition, ocular melanoma typically doesn't cause early signs or symptoms. Treatment for some small ocular melanomas may not interfere with your vision. However, treatment for large ocular melanomas typically causes some or complete vision loss in the effected eye.

Ocular melanoma commonly develops in the cells of the middle layer of the eye (uvea). The uvea has three parts and each can be affected by ocular melanoma: The iris, which is the colored part in the front of the eye. The choroid layer, which is the layer of blood vessels and connective tissue between the sclera and the retina at the back of the uvea. Ocular melanoma can also occur on the outermost layer on the front of the eye (conjunctiva), in the socket that surrounds the eyeball and on the eyelid.
Ocular melanoma treatment options are dependent on the location and size of the tumor.
Stephanie Walter OCULAR MELANOMA Foundation
Copyright © 2022 Stephanie Walter Ocular Melanoma Foundation - All Rights Reserved.
Powered by GoDaddy
We use cookies to analyze website traffic and optimize your website experience. By accepting our use of cookies, your data will be aggregated with all other user data.